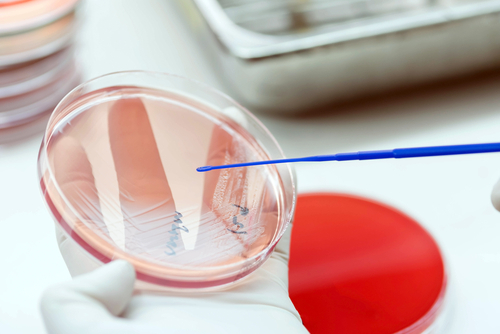

What's new for pneumonia? Five innovative antibiotics in the pipeline
M3 Global Newsdesk Apr 29, 2017
Here’s a look at five novel antibiotics currently in advanced stages of development (phase 3 and above) that show promise for treating CAP in adults over age 65.
Novel antibiotics currently in development hold promise for better treatment of community-acquired pneumonia in the elderly.Community-acquired pneumonia (CAP) disproportionately affects older people, with high rates of morbidity and mortality among the elderly. Although pneumococcal vaccines are routinely recommended for this population, fewer than 60% of adults age 65 and older get vaccinated. Thus, antibiotics are key to treating CAP in the elderly—and the earlier that antibiotic therapy starts, the better.
However, antibiotic treatment of CAP holds a number of challenges in the elderly, including compliance issues, immunosuppression, polypharmacy, and antimicrobial resistance. Few, if any, currently-available antibiotics can tackle all these challenges. But several antibiotics under development—if approved—may provide better and safer treatment.
Here’s a look at five novel antibiotics currently in advanced stages of development (phase 3 and above) that show promise for treating CAP in adults over age 65.
Lefamulin
A novel semisynthetic drug from the pleuromutilin class.
Pleuromutilin antibiotics have been used for decades in veterinary medicine to treat respiratory infections in swine and poultry. Pleuromutilins inhibit bacterial growth by binding to the peptidyl transferase center of the 50S ribosomal subunit—a binding site that’s unique to this antibiotic class. Pleuromutilins aren’t affected by resistance to other antibiotic classes (including macrolides, fluoroquinolones, tetracyclines, and others).
Thanks to its novel mechanism of action, lefamulin possesses potent activity against various gram-positive and gram-negative bacteria commonly associated with CAP, including multidrug-resistant strains.The drug has been developed by Nabriva Therapeutics in both intravenous (once daily) and oral (twice daily) forms for treatment of CAP. Recent results, reported by Nabriva, from the phase 3 LEAP 1 trial showed that lefamulin was comparable (non-inferior) to moxifloxacin for early clinical response (87.3% vs 90.2%), with or without adjunctive linezolid, in patients with community-acquired bacterial pneumonia. Treatment-related adverse events were also comparable (about 38%) in each treatment group.
“Due to lefamulin’s flexible dosing and targeted spectrum of activity against the pathogens most commonly associated with [community-acquired bacterial pneumonia], including multidrug-resistant strains, we believe that lefamulin is well suited to be a first-line empiric monotherapy,” said Nabriva CEO Colin Broom, BMBS, who added that lefamulin might well be the first in a new class of antibiotics for CAP in more than 15 years.
“We continue to execute on our second pivotal trial evaluating oral lefamulin for the treatment of [community-acquired bacterial pneumonia] CABP, with enrollment expected to complete in the fourth quarter of 2017 and topline results anticipated in the spring of 2018.”A second phase 3 clinical trial, LEAP 2, is currently enrolling patients, with a goal of releasing topline data in the spring of 2018. The trial will compare oral lefamulin with oral moxifloxacin in patients with moderate CAP.
Solithromycin
A fourth-generation macrolide and the first fluoroketolide in clinical development.
Solithromycin has demonstrated potent in vitro activity against the most common pathogens of CAP, including macrolide-, penicillin-, and fluoroquinolone-resistant isolates of Streptococcus pneumoniae, as well as Haemophilus influenzae, Moraxella catarrhalis, Legionella pneumophila, Mycoplasma pneumoniae, and methicillin-sensitive Staphylococcus aureus (MSSA).The drug was developed as both an oral form and intravenous form. A phase 3 trial for the treatment of patients with CAP demonstrated the oral form of solithromycin was comparable to oral moxifloxacin, which demonstrated “the potential to restore macrolide monotherapy for this indication.”
Gastrointestinal adverse events occurred in approximately 10% of patients. However, 5% to 10% of patients experienced elevation of transaminase—an indicator of liver damage. Although this generally resolved following cessation of therapy, it raised the specter of the hepatotoxic adverse events that have occurred with telithromycin (Ketek), a related ketolide antibiotic.As a result, in December 2016, the FDA declined to approve solithromycin in both oral and intravenous forms for patients with CAP. In a Complete Response Letter, the FDA recommended that the company initiate a new clinical study to better evaluate the drug’s safety profile and to “enable the exclusion” of drug-induced hepatotoxicity.
The company is now conducting a trial of solely oral solithromycin in 6,000 patients, with data from an additional 3,000 patients to be submitted later, including on a post-approval basis. If the oral version of the drug is approved (which is likely to take another two years), the company has the future option to seek approval for the intravenous form.Solithromycin is also being studied for treating gonorrhea and dry eye/blepharitis.
Nemonoxacin
A novel non-fluorinated quinolone that targets both topoisomerase II and IV, providing a broad spectrum of activity against gram-positive and gram-negative CAP pathogens.
Research has shown that nemonoxacin has activity similar to that of gemifloxacin, and is much better than that of levofloxacin and moxifloxacin against invasive S. pneumoniae. It possesses particular activity against methicillin-resistant S. aureus (MRSA) and vancomycin-resistant enterococci.
Nemonoxacin is available in once-daily dosing in oral and intravenous formulations, and appears to be well tolerated with few adverse events (possibly due to the drug’s absence of fluorine). China, Taiwan, the Russian Federation, Turkey, and Latin America have all approved nemonoxacin for treatment of adults with CAP. In December 2013, the FDA granted it fast track designation and Qualified Infectious Disease Product status for CAP and acute bacterial skin and skin structure infections.
“We believe that this antibiotic has great potential and a potential niche for use in the elderly population,” wrote respiratory care professor Marcos I. Restrepo, MD, MSc, and colleagues at the University of Texas Health Science Center, in San Antonio, TX, in an Expert Opinion on Pharmacotherapy article.
Omadacycline
A first-of-its-kind antibiotic from the aminomethylcycline class and a semisynthetic compound created by chemical modification of minocycline.
Although aminomethycyclines are related to tetracyclines, omadacycline has substitutions at the 7- and 9-positions on the tetracycline chemical structure. This enables it to be active against the two main forms of bacterial resistance to the tetracyclines: efflux and ribosomal protection.
Omadacycline has potent activity against a broad spectrum of bacteria, including common gram-positive and gram-negative CAP organisms. It’s also active against many multidrug-resistant bacteria (including those typically resistant to tetracyclines), such as community-acquired MRSA, β-hemolytic streptococci, penicillin-resistant S. pneumoniae, H. influenzae, and Legionella.
In April 2017, the drug’s developer, Paratek Pharmaceuticals, released results from a phase 3 clinical trial that compared once-daily oral and intravenous omadacycline to oral and intravenous moxifloxacin in adults with mild, moderate, and severe CAP. Results showed omadacycline was comparable to moxifloxacin (81.1% vs. 82.7%) for early clinical response (72 to 120 hours after initiation of therapy).Omadacycline was also comparable to moxifloxacin at the post-treatment visit 5 to 10 days after the completion of therapy.
Omadacycline was generally safe and well tolerated, the results showed. Drug-related adverse events occurred in 10.2% of patients in the omadacycline group vs 17.8% in the moxifloxacin group. The most common adverse events were ALT increase (3.7% for omadacycline vs 4.6% for moxifloxacin) and hypertension (3.4% vs 2.8%). Gastrointestinal adverse events included vomiting (2.6% vs 1.5%), nausea (2.4% vs 5.4%), and diarrhea (1% vs 8%). No cases of clostridium difficile colitis or infection occurred in patients given omadacycline, compared with seven cases (1.8%) in patients given moxifloxacin.
“Antibiotic resistance is a national issue as susceptibility rates have decreased across most antibiotics since 2010, underscoring the need for new, effective therapies,” said Thomas M. File, Jr., MD, MS, Chair of the Division of Infectious Disease at Summa Health System, in Akron, OH, and a consultant to Paratek. “The positive top-line results of omadacycline in community-acquired bacterial pneumonia is welcome news.”
Delafloxacin
A novel, broad-spectrum and highly potent fluoroquinolone that’s unlike other fluoroquinolones.
This is due to certain structural differences that (1) increase its activity in acidic environments, (2) stabilize the molecule, and (3) increase its molecular surface compared with other quinolones. As such, it moves better than other fluoroquinolones through an acidic medium, which facilitates an easier transmembrane passage into the bacterium.
Delafloxacin has a high affinity for both topoisomerase IV and DNA gyrase targets, giving it formidable activity against gram-positive bacteria (S. aureus, S. pneumoniae, β-hemolytic streptococci, and some Enterococcus species), gram-negative bacteria (H. influenzae, M. catarrhalis, N. meningitidis, N. gonorrhoeae, Enterobateriaceae, and Pseudomonas species), as well as anaerobes and intracellular microorganisms. It also inhibits production of staphylococci biofilms.
In June 2017, the FDA approved delafloxacin for adults with acute bacterial skin and skin structure infections (ABSSSI). In terms of adverse events, phase 2 and phase 3 trials of delafloxacin for bacterial skin infections showed that nearly half (47.7%) of subjects had one or more drug-related adverse events. The most common were nausea (8%), diarrhea (8%), headache (3%), transaminase elevations (3%), and vomiting (2%). The dosage should be decreased in patients with severe renal impairment, according to the drug’s prescribing information.A phase 3 trial is now underway to determine if delafloxacin is effective for CAP compared with moxifloxacin, or linezolid in the case of confirmed MRSA.
Delafloxacin is available in both intravenous and oral forms with twice-daily dosing. Due to its high activity against pneumococci and atypical pathogens, the FDA gave it fast-track status and designated it as a Qualified Infectious Disease Product for CAP treatment.As with other fluoroquinolones, a boxed warning on the label advises the potential for serious adverse reactions of tendinitis, tendon rupture, peripheral neuropathy, central nervous system effects, and exacerbations of myasthenia gravis related to fluoroquinolones.
In summary, these novel antibiotics generally have more potent antimicrobial activity, better efficacy against resistant pathogens, enhanced safety profiles, and superior pharmacokinetics than current antibiotics. Only time—and the FDA—will tell if these new drugs will become first-line therapies.
This story is part of our Global Content Initiative, where we will feature selected stories from our Global network which we believe would be most useful and informative to our doctor members.
-
Exclusive Write-ups & Webinars by KOLs
-
Daily Quiz by specialty
-
Paid Market Research Surveys
-
Case discussions, News & Journals' summaries